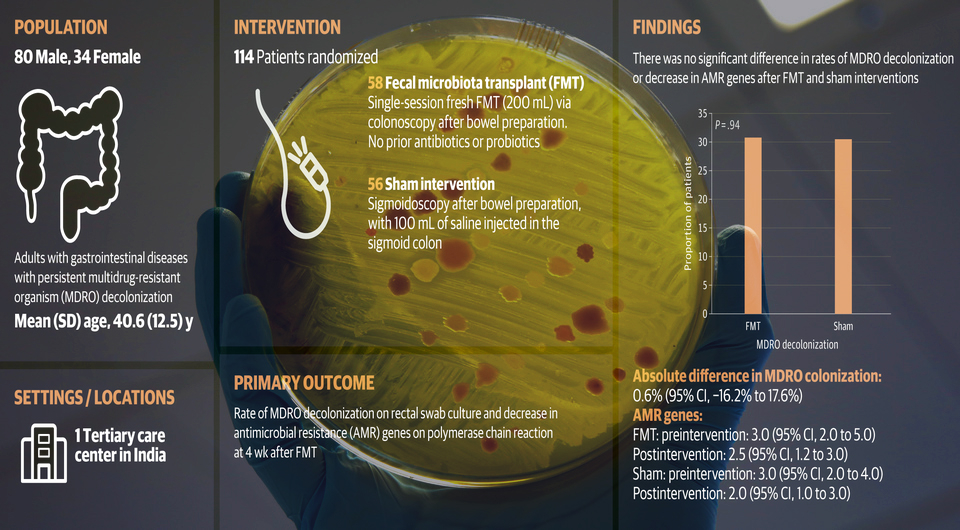

Химаншу Наранг (Himanshu Narang) из Всеиндийского института медицинских наук и его коллеги провели клинические испытания и выяснили, что трансплантация фекалий не уменьшает колонизацию кишечника бактериями с множественной лекарственной устойчивостью.
В двойных слепых рандомизированных контролируемых испытаниях приняли участие 114 пациентов (средний возраст 40,6 года; 70,2 процента — мужчины; 45,6 процента с панкреатитом; 37,7 процента с циррозом печени; 16,7 процента с другими желудочно-кишечными заболеваниями) с антибиотикоустойчивыми кишечными бактериями. У большинства из них (97,4 процента) это были устойчивые к карбапенему или продуцирующие бета-лактамазу расширенного спектра представители семейства Enterobacteriaceae. Половине участников однократно выполнили пересадку кала от здоровых доноров, другой половине — ее симуляцию. Результаты опубликованы в журнале JAMA Internal Medicine.
Пять участников не явились на повторное обследование, остальные были включены в итоговый анализ. Он продемонстрировал отсутствие значимой разницы между основной и контрольной группами в деколонизации кишечника бактериями с множественной лекарственной устойчивостью (31,0 против 30,4 процента; p = 0,94) и среднем числе генов антибиотикоустойчивости в их фекальной микробиоте (2,5 против 2,0; p = 0,68) через четыре недели после процедуры. У 71 пациента, которым выполнили секвенирование бактериальной 16S рибосомальной РНК, после пересадки кала наблюдалось обогащение микробиоты, синтезирующей короткоцепочечные жирные кислоты. Процедура не влияла на разнообразие вирома и вызывала лишь умеренные и преходящие изменения состава микобиома.
https://nplus1.ru/news/2026/04/24/fecal-transplant-resistance
|